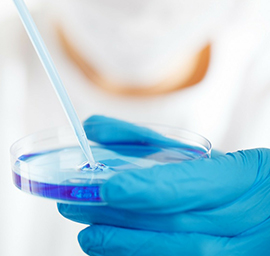

专注生物医药领域
的专业投资机构
的专业投资机构

公司简介
杭州十棱投资管理有限公司(简称“十棱投资”或“TENEDGE”)是一家专注生物医药领域的专业投资机构,公司将积聚海内外政府、资本、行业、技术和人才资源,致力于为优秀创业企业提供发展所需资本及成熟的管理经验,帮助企业快速成长,建立领先优势。
帮助企业快速成长,建立领先优势。

公司将积聚海内外政府、资本、行业、技术和人才资源,致力于为优秀创业企业提供发展所需资本及成熟的管理经验。
专业创造价值

奉行稳健、创新、严谨的投资哲学,团队成员均拥有10年以上的专业投资经验,拥有丰富的创投管理经验和众多经典案例,公司管理具有完整的募投管退的管理运营体系。
一体化专业服务

与国内外众多知名投资机构、上市公司、基金公司、银行及著名高等院校有着良好的关系,与知名的投资银行、券商、律师事务所、会计师事务所等中介机构建立了稳固的业务合作模式。

投资理念
-
我们是什么
专注于生物医药领域的专业投资机构
-
我们的核心价值观
诚信、专业、创新、卓越

-
我们的愿景
致力于成长为一家精美的生物医药投资公司
-
我们的服务理念
专心、专注、专业、专家
投资领域
新药研发

精准医疗

医疗器械

生物技术
合作伙伴


诚聘英才
加入十棱投资,你能和一群有好奇心的聪明人一起做事。在这里,没有层级障碍,你随时都可以提出自己的想法和创意。我们鼓励内部创业,创业的氛围激发着十棱投资的每一个人去努力创新。十棱投资提供良好的薪酬福利和系统的培训体系,致力于把你培养成优秀的投资人和基金管理人!目前我们公司正处于起步展阶段,假如你有梦想、有激情、热爱充满挑战的生物医药创投事业,欢迎加入我们团队,与我们共同成长!
欢迎和期待你加入我们的行列!
请将简历投递至hr@tenedge.com或登录前程无忧网站应聘。

高级投资经理/投资总监

投资助理/投资经理

实习生
接受应届毕业生
联系我们
杭州市滨江区江汉路1785号网新双城大厦1幢2101室
BP@tenedge.com
0571-86930449